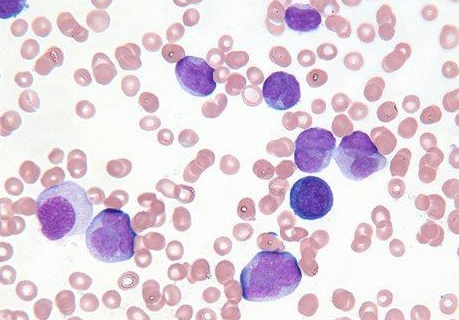

先前的研究表明,威托克可以提高抗白血病细胞的活性。因此,我们假设威托克促进白血病化疗的效果并降低复发风险而无并发症。
在研究和调查中,有9名患者患有高危急性髓细胞白血病(AML)和骨髓增生异常综合征(MDS),医生建议患者进行干细胞移植。在第一阶段的临床试验中,患者接受了威托克化疗和夫拉达滨( fludarabine)、白舒非(busulfex)预处理疗法。之后,将进行干细胞移植。研究人员说:“我们发现威托克可以加入到低强度条件治疗中,并且不会干扰供体中性粒细胞(一种白细胞)的增殖。由于患者离移植手术只有6个月的时间,因此仍然无法确定威托克能否降低白血病的复发率。
然而,中性粒细胞数量的显著增加对患者或疾病研究是有益的。目前,在这种低强度的治疗中没有发现毒性反应或移植物抗宿主反应。
威托克药品详细信息请进入:https://www.inmedf.com/zhongliu/bxb/20201419.html